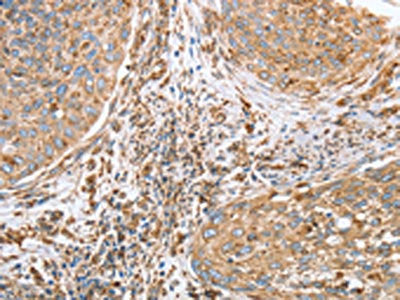
The image on the left is immunohistochemistry of paraffin-embedded Human cervical cancer tissue using CSB-PA106469(CANX Antibody) at dilution 1/40, on the right is treated with fusion protein. (Original magnification: ×200)

Product Overview
Product Overview
Alternative names
Calnexin antibody; CALX_HUMAN antibody; CANX antibody; CNX antibody; FLJ26570 antibody; Histocompatibility complex class I antigen binding protein p88 antibody; IP90 antibody; Major histocompatibility complex class I antigen-binding protein p88 antibody; p90 antibody
Antigen
Fusion protein of Human CANX
Buffer
pH7.4 of PBS, 0.05% NaN3, 40% Glycerol.
Clonality
Polyclonal
Clone number
N/A
Conjugated
Non-conjugated
Form
Liquid
Host species
Rabbit
Isotype
IgG
Purification method
Antigen Affinity Purified
Research area
Tags & Cell Markers
Species
Human
Species reactivity
Human, Mouse, Rat
Storage
Upon receipt, store at -20°C or -80°C. Avoid repeated freeze.
Target name
CANX
Tested applications
ELISA, WB, IHC; ELISA:1:2000-1:5000, WB:1:500-1:2000, IHC:1:50-1:200
Uniprot id
P27824
Documents
Documents
Background
Background
Target: CANX. Antigen: Fusion protein of Human CANX. Reactivity: Human, Mouse, Rat. Applications: ELISA, WB, IHC; ELISA:1:2000-1:5000, WB:1:500-1:2000, IHC:1:50-1:200. Polyclonal IgG Clone N/A.
Product Citations
Product Citations
More Info
More Info
CANX Antibody
CANX Antibody
Regular price
$166.00 USD
Sale price
$166.00 USD
Regular price
Unit price
/per
Shipping calculated at checkout.
Available in stock (500)
Request a Quote
✅ Thank you! Your quote request was sent successfully.
❌ Something went wrong. Please check your details and try again.
- Customs clearance fees may apply
- Worldwide shipping available.
Couldn't load pickup availability
For research use only — not intended for clinical or diagnostic purposes.
Product Overview
Product Overview
Alternative names
Calnexin antibody; CALX_HUMAN antibody; CANX antibody; CNX antibody; FLJ26570 antibody; Histocompatibility complex class I antigen binding protein p88 antibody; IP90 antibody; Major histocompatibility complex class I antigen-binding protein p88 antibody; p90 antibody
Antigen
Fusion protein of Human CANX
Buffer
pH7.4 of PBS, 0.05% NaN3, 40% Glycerol.
Clonality
Polyclonal
Clone number
N/A
Conjugated
Non-conjugated
Form
Liquid
Host species
Rabbit
Isotype
IgG
Purification method
Antigen Affinity Purified
Research area
Tags & Cell Markers
Species
Human
Species reactivity
Human, Mouse, Rat
Storage
Upon receipt, store at -20°C or -80°C. Avoid repeated freeze.
Target name
CANX
Tested applications
ELISA, WB, IHC; ELISA:1:2000-1:5000, WB:1:500-1:2000, IHC:1:50-1:200
Uniprot id
P27824
Documents
Documents
Background
Background
Target: CANX. Antigen: Fusion protein of Human CANX. Reactivity: Human, Mouse, Rat. Applications: ELISA, WB, IHC; ELISA:1:2000-1:5000, WB:1:500-1:2000, IHC:1:50-1:200. Polyclonal IgG Clone N/A.
Product Citations
Product Citations
More Info
More Info

CANX Antibody
Regular price
$166.00 USD
Sale price
$166.00 USD
Regular price
Unit price
/per